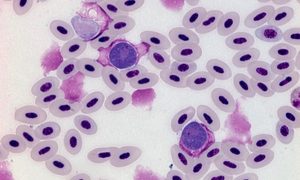

昆虫類
昆虫類 ブユの症状 ~ ブユの多数の飛来・吸血によって悩まされ、不安状態となります
ブユは温暖な夏季に活躍し、主に早朝と夕刻に動物を襲います。動物はブユの多数の飛来・吸血によって悩まされ、不安状態となり、家畜では生産性の低下も現れます。大動物では頭部、四肢、腹部、乳房部が好む刺咬部位であり、これらの局所に刺咬による強い痒覚...
 昆虫類
昆虫類 原生動物
原生動物  鶏用ワクチン一覧・ワクチンについて
鶏用ワクチン一覧・ワクチンについて